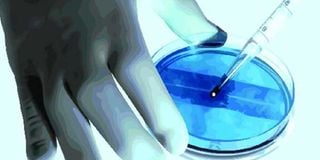

Premium
You can easily avoid getting cancer of cervix
HPV can affect anyone who is sexually active — it does not matter whether one has one or multiple sex partners. However, the risk of getting infected with HPV is higher in those with multiple partners. PHOTO | FILE
What you need to know:
- HPV is among the most common sexually transmitted infections, with mote than 50 per cent of adults (men and women) who are sexually active having it at least once in their lifetime.
Nearly all cases of cancer of the cervix are due to the Human Papilloma Virus (HPV).
HPV is among the most common sexually transmitted infections, with mote than 50 per cent of adults (men and women) who are sexually active having it at least once in their lifetime.
There are more than 100 forms of HPV, and more than 40 of them affect the genitals.
HPV can lead to various infections — including cervical cancer and genital warts (characterised by small bumps that normally appear on the genital area).
Worth noting is that the types of HPV that lead to cervical cancer differ from those that cause genital warts. Like other sexually transmitted diseases, HPV is contagious.
It can be passed on via sexual contact (vaginal, anal or oral sex) or contact with the bodily fluids of an infected person. One can also pass the virus to a sexual partner without one’s knowledge.
Normally, in about 90 per cent of HPV infections, the body’s immune system is able to clear the virus — meaning that one doesn’t realise they have been infected.
The risk of this happening is that, if HPV is untreated, it can lead to unusual changes in the cells in the cervix, something that can lead to cervical cancer.
HPV can affect anyone who is sexually active — it does not matter whether one has one or multiple sex partners. However, the risk of getting infected with HPV is higher in those with multiple partners.
In addition, those who have sex at a young age are more at risk of getting the virus. Having not been vaccinated against it also heightens the risk of infection.
Contrary to common belief, HPV affects anyone, young and old. But you can avoid infection as well as complications associated with it by getting vaccinated, regularly screening for cervical cancer and staying in a monogamous relationship or practising safe sex.
HPV vaccines are especially important because they protect against the virus. They are administered through an intramuscular injection on the upper arm in a series of three shots over a six- to seven-month period.
Primary vaccination of HPV is recommended between nine and 14 years. When given at this age, there is an opportunity to develop an immune response to the infection prior to becoming sexually active.
Between ages 14 and 26, a catch-up vaccine can be given if one missed the primary vaccine.
After 26 years, however, the vaccine might not be as effective in protecting against HPV as it would if received earlier. This is why screening for cervical cancer (Pap test) is recommended after 26 years.
Like most vaccines, the HPV one might have some side effects — including mild fever and mild pain on the point of injection. Nevertheless, these can be easily managed at home by taking over-the-counter painkillers such as paracetamol.
Do you have a question about your health? Send it to [email protected]




